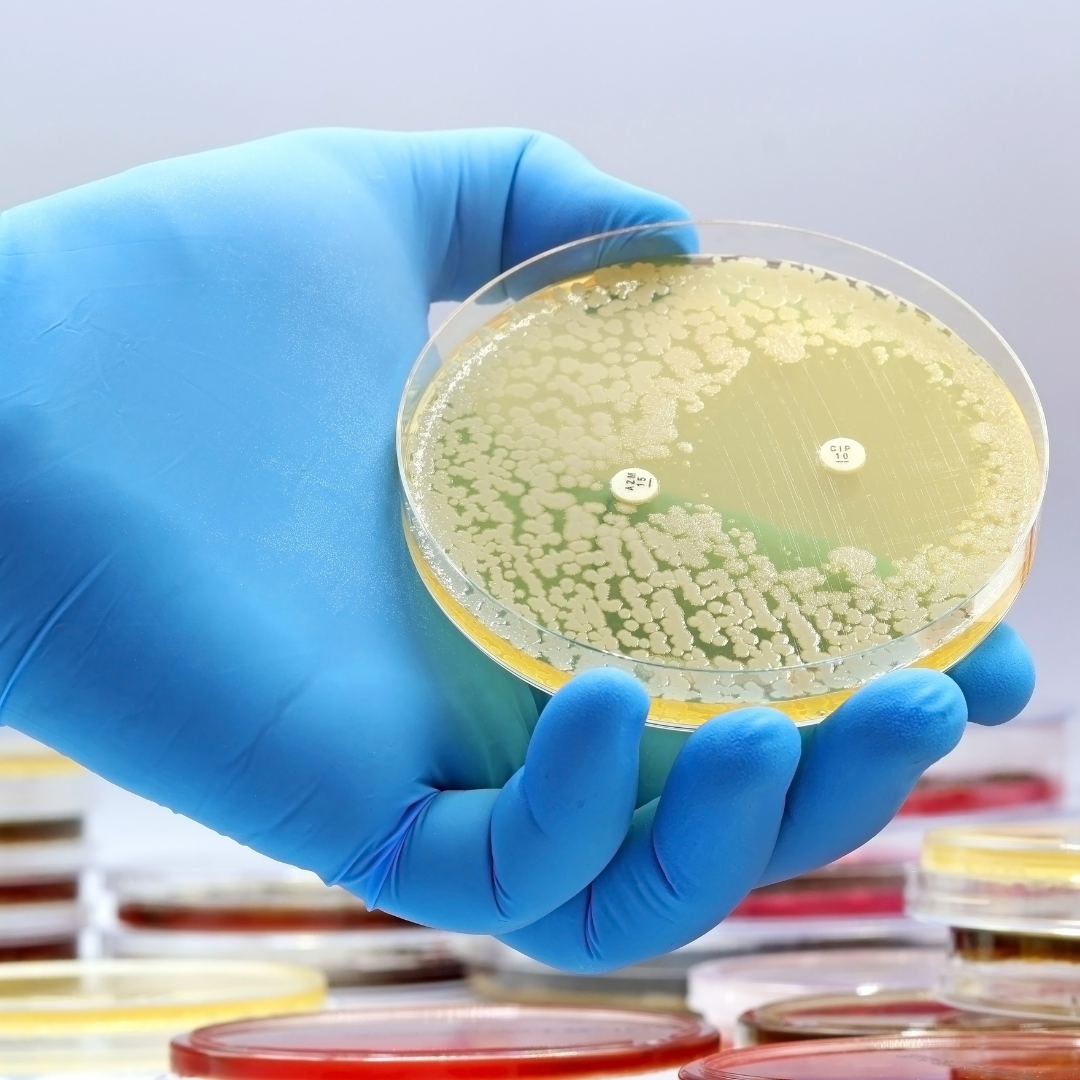
micobactérias não tuberculosas

As micobactérias não tuberculosas (MNT) são um grupo de bactérias que pertencem ao gênero Mycobacterium. Elas não são responsáveis pela tuberculose, mas podem provocar infecções em pessoas que estejam com sistema imunológico comprometido ou que possuem outras doenças, como a fibrose cística.
Por serem disseminadas na natureza (água, solo e poeira), acredita-se que a fonte de infecção das MNT em humanos seja o meio ambiente e as pessoas não transmitam as micobactérias. Mais de 170 espécies de micobactérias não tuberculosas já foram encontradas, sendo as principais delas Mycobacterium avium complex, Mycobacterium kansasii e Mycobacterium marinum.
Os principais sintomas das micobactérias não tuberculosas, que podem variar de acordo com a espécie e o local da infecção, são tosse persistente, dispneia, hemoptise, febre, perda de peso e fadiga.
É comum ter contato com as micobactérias não tuberculosas no dia a dia, mas na maioria dos casos, isso não leva ao desenvolvimento de uma infecção. Muitas vezes, mesmo quando a pessoa se infecta, ela não desenvolve a doença.
Para que uma infecção se torne uma doença, geralmente é preciso que o sistema imunológico da pessoa esteja enfraquecido ou ela já tenha alguma condição de saúde. Ou seja, a probabilidade das MNT causarem doença pulmonar é maior na presença de fatores associados, como Doença Pulmonar Obstrutiva Crônica (DPOC), fibrose cística, bronquiectasias e até mesmo o transplante.
De acordo com a Recomendações para o Diagnóstico e Tratamento das Doenças Causadas por Micobactérias não Tuberculosas no Brasil, documento criado pelo Ministério da Saúde, é possível que exista a indicação para que pessoas com quadros estáveis da fibrose cística realizem anualmente a cultura para micobactérias no escarro espontâneo.
Além disso, o documento ainda afirma que não é incomum que mais de uma espécie de MNT seja isolada em uma pessoa com a doença. Nessas situações, o seguimento de culturas deve ser feito para determinar qual espécie é persistentemente positiva.
A identificação da espécie específica de MNT que está causando a infecção na pessoa com fibrose cística é um aspecto fundamental para a definição do tratamento. Isso acontece pois diferentes espécies podem exigir diferentes cuidados.
Por isso, caso tenha dúvidas sobre a identificação e tratamento para as micobactérias não tuberculosas na fibrose cística, busque ajuda da sua equipe médica no Centro de Referência.
Por Kamila Vintureli
Referências:
https://www.scielo.br/j/jbpneu/a/FNMxhMXRDVMYHHf4L8GKYfM/?lang=pt&format=pdf
Quer fortalecer o trabalho realizado pelo Unidos pela Vida? Clique aqui e escolha a melhor forma de fazer uma doação.
Nota importante: As informações aqui contidas têm cunho estritamente educacional. Em hipótese alguma pretendem substituir a consulta médica, a realização de exames e/ou o tratamento médico. Em caso de dúvidas, fale com seu médico.
Segunda à sexta | 9h às 18h
O time do Unidos pela Vida atua em home office. Caso precise falar conosco, utilize um dos meios de contato.
Inscreva-se em nossa newsletter para receber notícias, avisos, alertas importantes e fique por dentro de tudo que acontece em nosso grupo: